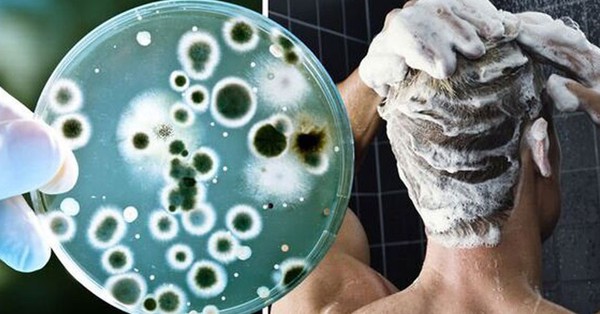

Bác sĩ cảnh báo, việc giữ phòng tắm sạch sẽ có ý nghĩa vô cùng quan trọng với sức khỏe của bạn.
Khi đi công tác và phải ở lại qua đêm, bạn quên mang theo khăn, bàn chải hay dao cạo. Bạn có thể muốn mượn của đồng nghiệp để tránh phải mua đồ mới chỉ dùng một đêm. Tuy nhiên, các chuyên gia khẳng định 3 thứ vật dụng cá nhân phổ biến này trong phòng tắm tuyệt đối không được dùng chung để tránh nguy cơ lây nhiễm.
Tiến sĩ danh dự Thea van de Mortel, Giáo sư danh dự về Điều dưỡng tại Đại học Griffith (Úc), đã viết trên trang The Conversation rằng, nhiều vi khuẩn, virus hoặc nấm gây bệnh thường ký sinh trên các vật liệu vải, nhựa và kim loại trong phòng tắm.

Ảnh minh họa
Các vi sinh vật gây bệnh này có thể tồn tại trên các bề mặt này trong thời gian dài. Điều đó có nghĩa là chúng có khả năng gây nhiễm trùng trong vài ngày, vài tháng, thậm chí vài năm.
Ví dụ, nấm Aspergillus có thể tồn tại trên vải và nhựa hơn một tháng. Một số vi khuẩn có thể tồn tại trên các bề mặt này trong vài năm. Nhiều loại virus có thể sống sót trên các vật liệu như gốm, kim loại, vải và nhựa từ vài giờ đến vài tháng.
Vậy, cụ thể việc sử dụng chung các vật dụng cá nhân như khăn tắm, bàn chải hoặc dao cạo râu có nguy cơ gì?
3 thứ tuyệt đối không nên dùng chung trong phòng tắm
1. Khăn tắm (Towels)
Một báo cáo ở Mỹ chỉ ra rằng, một nhóm cầu thủ bóng bầu dục trung học đã bị nhiễm vi khuẩn Staphylococcus aureus (tụ cầu vàng). Những cầu thủ dùng chung khăn tắm có nguy cơ nhiễm vi khuẩn này cao gấp 8 lần so với các cầu thủ khác.
Staphylococcus aureus có thể gây ra bệnh ngoài da như chốc lở (impetigo). Trong những trường hợp hiếm hoi, nó có thể dẫn đến sốc nhiễm trùng và suy nội tạng đe dọa tính mạng.

Ảnh minh họa
Trong một nghiên cứu khác ở Mỹ, các nhà nghiên cứu đã theo dõi 150 gia đình trong 12 tháng, mỗi gia đình đều có một trẻ em nhiễm Staphylococcus aureus. Họ phát hiện ra rằng, nguy cơ lây lan vi khuẩn này tăng lên đáng kể khi các thành viên trong gia đình dùng chung khăn tắm.
Mặc dù tắm bằng xà phòng và nước có thể làm giảm số lượng vi sinh vật trên da nhưng không thể loại bỏ hoàn toàn. Hơn nữa, môi trường ấm áp và ẩm ướt trong phòng tắm thông thường còn tạo điều kiện cho vi sinh vật phát triển.
2. Bàn chải đánh răng (Toothbrushes)
Vi sinh vật có thể sống sót trên các vật cứng như bàn chải đánh răng. Bàn chải đánh răng có thể gây chảy máu nướu, vì vậy không nên dùng chung bàn chải vì điều này có thể lây truyền các virus lây truyền qua đường máu, như viêm gan C.
Không phải tất cả những người thuộc nhóm nguy cơ cao nhiễm viêm gan C đều được xét nghiệm. Hơn nữa, ngay cả khi không có triệu chứng, người bệnh vẫn có khả năng lây nhiễm.

Ảnh minh họa
Bất kỳ vật dụng nào tiếp xúc với nước bọt (ví dụ: bàn chải đánh răng) cũng có thể lây truyền mầm bệnh. Những mầm bệnh này bao gồm virus Herpes Simplex loại 1 (HSV-1). Ngay cả khi không có dấu hiệu nhiễm HSV-1, bệnh nhân vẫn có thể truyền virus và lây nhiễm cho người khác.
Nghiên cứu đã phát hiện ra rằng bàn chải đánh răng có thể bị ô nhiễm bởi các vi khuẩn như Staphylococcus, E. coli và Pseudomonas. Số lượng HSV-1 trên bàn chải cũng đủ để gây nhiễm trùng. Loại virus này có thể tồn tại trên vật liệu nhựa từ 2 đến 6 ngày.
3. Dao cạo râu (Razors)
Vi sinh vật cũng có thể tồn tại trên các vật cứng như dao cạo râu. Hơn nữa, rất khó để tránh khỏi việc bị trầy xước khi sử dụng dao cạo. Do đó, việc dùng chung dao cạo râu có thể lây truyền các loại virus lây truyền qua đường máu.

Ảnh minh họa
Ai là nhóm người có nguy cơ nhiễm trùng cao?
Tiến sĩ Mortel cho biết, các nhóm sau đây đặc biệt dễ bị nhiễm trùng do dùng chung các vật dụng vệ sinh cá nhân:
Trẻ sơ sinh - Hệ thống miễn dịch của trẻ vẫn đang phát triển.
Người lớn tuổi - Chức năng miễn dịch suy giảm khi về già
Người đang dùng thuốc ức chế miễn dịch - Bao gồm thuốc chống ung thư, corticosteroid uống và thuốc dùng sau khi cấy ghép nội tạng.
Bệnh nhân tiểu đường tuyp 2—Do lượng đường trong máu cao làm suy giảm chức năng của các tế bào miễn dịch và các phân tử liên quan.
Tiến sĩ Mortel kết luận: Nếu bạn dùng chung khăn tắm, bàn chải hay dao cạo râu với người khác, bạn sẽ thường xuyên tiếp xúc gần và chia sẻ vi sinh vật với họ. Mặc dù nguy cơ nhiễm trùng tổng thể là thấp, nhưng tốt nhất vẫn nên hình thành thói quen không bao giờ dùng chung các vật dụng vệ sinh cá nhân, nhất là 3 thứ nói ở trên.

Thời gian đánh răng, rửa mặt, tắm rửa, vệ sinh quá lâu hay quá chậm cũng có những bất lợi đối với sức khỏe.
Theo Abolouwang